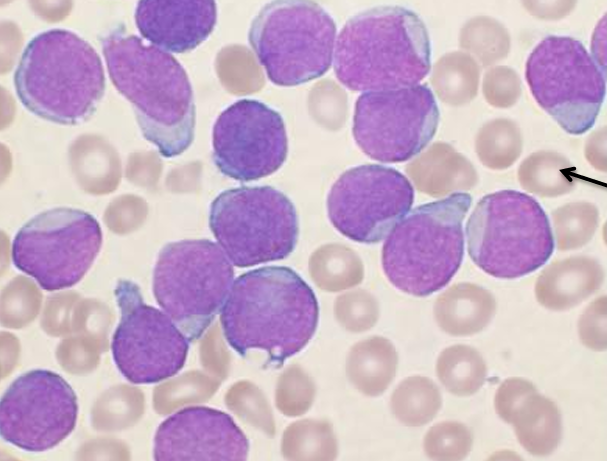
<p>Most common cancer in children, causing rapid proliferation of pre-B lymphoblasts in bone marrow</p><p><u>Pathogenesis</u>: numerical or structural chromosomal changes causing bone marrow to be packed with rapidly dividing pre-B lymphoblasts which fail to mature</p><p><u>Diagnosis</u>:</p><ul><li><p>Anaemia, neutropenia, thrombocytopenia (pancytopenia)</p></li><li><p>Bone pain</p></li><li><p>Lymphadenopathy, splenomegaly, hepatomegaly</p></li><li><p>Blood film and biopsy: circulating lymphoblasts</p></li><li><p>Immunohistochemistry: TdT, CD10, CD19, CD20</p></li></ul><p><u>Treatment</u>: invasive chemotherapy followed by consolidation and maintenance</p><p><u>Prognosis</u>: if hyperdiploidy (>50 chromosomes/ cell) - good prognosis</p><p></p>

1/37
Looks like no tags are added yet.
Name | Mastery | Learn | Test | Matching | Spaced | Call with Kai |
|---|
No study sessions yet.
Guillain-Barre Syndrome
(definiton + pathogenesis + causes + signs + treatment)
Rapidly progressing, acute demyelinating disorder affecting peripheral motor axons
Pathogenesis: humoral and T-cell mediated immune response and macrophage activation which attacks schwann cells and engulfs myeline sheath, causing segmental degeneraion
Causes: Campylobacter infection, CMV, EBV, HIV, prior vaccinations
Signs:
Weakness and paralysis starting in distal limbs
Advances proximally
Treatment:
Paramapharesis
IV immunoglobulins and steroid therapy

Diabetic neuropathy
(pathogenesis + signs + complications)
Pathogenesis: metabolic and ischaemic damage to nerves due to thickening of endoneurial arterioles from diabetes
Signs:
Distal, symmetrical polyneuropathy: numbness, loss of pain sensation
Autonomic neuropathy: disturbances in bladder and bowel function
Complications: can lead to infection and amputation

Amyotrophic lateral sclerosis (ALS)
(definiton + pathogenesis + signs + clinical progression)
Progressive neurological disorder causing selective degeneration of motor neurons responsible for voluntary muscle activity
Pathogenesis:
Poorly understood, related to superoxide dimutase (SOD1) mutations on chromosome 21 causing neural inclusions and cytotoxicity
LMN disease: atrophy of ventral spinal nerve roots causing skeletal muscle denervation
UMN Disease: degeneration of corticospinal tracts in lateral portion of SC
Signs:
LMN disease: weakness, fasciculations
UMN disease: paresis, hyperreflexia, spasticity, +ve babinski sign
Clinical progression:
Increasing muscle weakness and decrease in muscle bulk
Difficulty in deglutition and speaking
Recurrrent chst infection (main cause of death)

Diffuse axonal injury (pathogenesis + morphology + signs)
Pathogenesis: sudden severe deceleration of the brain causing disruption or shearing of axons
Morphology:
Macroscopic: brain oedema, splinter haemorrhages
Microscopic: retraction balls
Signs:
Immediate coma following injury
Signs of raised ICP (headache, confusion, nausea, papiledema)
Traumatic vascular injury (epidural, subdural, subarachnoid)
(pathogenesis + signs + CT + treatment)
Pathogenesis:
Epidural haematoma: tearing of middle meningeal arterty following fracture of temporal bone, where arterial pressure forms rapidly expanding haematoma
Subdural haematoma: rupture of bridging veins (usually in elderly patients with cerebral atrophy)
Subarachnoid haematoma: injury to BV (e.g. burst aneurysm) in subarachnoid space
Diagnosis - signs:
Epidural haemtoma: coma hours after injury
Subdural haematoma: coma days after injury
Signs of raised ICP
Diagnosis - CT:
Epidural haemorrhage: hyperdense biconvex mass stopping at suture line, midline hift and ventricular compression
Subdural haemorrhage: hyperdense/ isodense sick shape over cerebal convexity, midline shift and ventricular compression
Subarachnoid haemorrhage: star-shapped appearance around circle of willis; severe ‘thunderclap’ headache
Treatment:
Treatment of primary brain/ SC injury
Treatment and prevention of secondary injuries e.g. phenytoin (seizure prophylaxis)
Monitor clinical progression: debdridement of skull fractures, evacuation of haematoma
Types of brain herniations (definition + signs)
Subfalcine herniation: displacement of cingulate gyrus under falx cerebri
Transtentorial herniation: herniation of uncus of medial temporal lobe through tentorial notch, causing pressure on rostral midbrain
Signs:
Ipsilateral dilated and unresponsive pupil
Contralateral hemiparesis
Kernohan’s phenomenon: ipsilateral hemiparesis
Decreases consciousness or coma
Signs of raised ICP
Tonsilar herniation: herniation of inferior medial aspects of cerebellum through foramen magnum
Can cause compression of medulla causing cardiac/ respiratory depression and death

Glioblastoma
(definition + signs + diagnosis)
Grade IV astrocytoma
Signs of brain tumours
Seizures
Worsening vision
Sensory and motor abnormality
Headache
Stroke-like symptoms
Diagnosis
CT shows ring-like contrast enhancement aginst central necrosis
Biopsy shows pleomorphism, high cellularity and infiltration of tumour cells, palisaded necrosis and microvascular proliferation

Meningioma
(defintion + diangosis)
Benign, non-infiltrating tumour frmed by extra-axial meningothelial cells
Diagnosis:
CT shows dura-based, well-circumsised mass which does not invade underyling brain
Biopsy: meningothelial cells show whorled appearance with psamomma bodies

Brain abscess
(definition + signs + treatment)
infection of the brain causing necrosis and abscess formation
Signs:
Fever
Headache
Change in mental state
Focal neurological deficits
Seizures
Nausea and vomiting
Neck stiffness
Treatment:
Surgical drainage of abscess
Antiobiotic therapy
Elimination of primary site of infection
Ischaemic stroke (focal)
(definiton + causes + diagnosis + treatment)
Obstruction of blood supply to a localised area of the brain for a long enough period of time
Causes:
Embolic (20%): from heart, aorta and carotid arteries, paradoxical emboli
Thrombosis (80%): usually non-haemorrhagic
Diagnosis:
Signs: FAST
CT appaears hypodense on side of lesion
Treatment:
Stabilisation: maintain airways (ventilator, endotracheal tube, O2, monitor glucose, BP, hydration)
If ischaemic <8 hours: alteplase + mechanical thrombectomy
<9 hours if surviving penumbra, <4.5 hours if no surviving penumbra
Aspirin/ clopidogrel after 24hrs of alteplase administration
Management of comorbidities (e.g. AF, MI, HTN, diabetes)
Physiotherapy, OT, speech therapy

Alzheimer’s disease
(signs + pathogenesis)
Signs:
Short-term memory loss
Impairment of visuospatial skills
Disorientation, word-finding difficulty
Ultmate loss of mobility and speech
Diffuse cerebral atrophy
Biopsy shows NFT’s and neuritic plaques
Pathogenesis: extrcellular deposition of AB peptides which aggregate to form amyloid fibrils. These cause neuronal injury and dysfunction, and stimulate an inflammatory response causing neuronal damage and phosphorylation → aggregation of tau proteins
Sporadic, late-onset AD: ApoE gene on chr 19
FAD: APP, PSEN1/PSEN2 gene

Huntington’s disease
(defintion + pathogenesis + age of onset + signs)
Progressive and fatal autosomal dominant disease clinically characterised by progressive movement disorder and dementia
Pathogenesis: mutation on HD gene of chr4 which normally encodes for huntingtin protein, resulting in >40 CAG repeats. This causes formation of intraneuronal inclusions on huntingtin protein
Age of onset: 25-45 yrs
Signs:
Signs of dementia
Chorea
Macroscopic morphology shows atrophy of caudate and compensatory dilation of ventricles
Creutzfeld-Jakob disease
(definiton + pathogenesis + source of infection + signs)
Infectious prion disease causing rapid onset of fatal dementia
Pathogenesis:
Spontaneous conformational change from normal to abnormal prion protein
Prions bind to other normal prions which progressively reproduc and form aggregates
Sources of infection:
Contaminated corneal transplants
Dura mater grafts
Human growth hormone
Signs:
Onset 50-75 yrs
Rapidly progressing dementia with myoclonus
Biopsy shows spongiform transformation of cortex

Post-streptococcal GN
(definition + pathogenesis + diagnosis)
Glomerulonephritis with nephritic syndrome appearing 1-4 weeks following skin/ pharyngeal infection from GAS
Pathogenesis:
Host immune response to pathogenic antigen causes immune complex deposition in a subendothelial location (which migrates to subepithelial)
Subsequent complement activation and inflammation causes proliferation of endothelial and mesangial cells
Diagnosis:
Fever, malaise, nausea
Nephritic syndrome: oliguria, haematuria, mild proteinuria, mild-moderate HTN
Elevated tiers of anti-streptococcal Ab’s and low serum C3
Periorbital oedema
Urinalysis shows red cell casts
Biopsy shows enlarged, hypercellular glomerulus with subepithelial immune complex deposit, granular immunofluorescence

Membranous nephropathy
(definiton + pathogenesis + diagnosis + treatment)
Glomerulonephritis with nephrotic syndrome
Pathogenesis:
75% of cases HLA-related autoimmune
Accumulation of IgG-containing immune complex deposits in subepithelial location. These become incorporated into the GBM causing thickening
Activation of complement cascade including C5-C9 MAC. This releases proteolytic enzymes which damage foot processes causing proteinuria
NO inflammatory cells recruited as C3a + C5a not on capillary side of BM (cannot travel)
Diagnosis:
Nephrotic syndrome: heavy proteinuria, hypoalbuminemia, generalised oedema, hyperlipidemia and lipiduria
Biposy of kidney shows thickened GBM, spiked appearance, no inflammatory cells, granular immunoflurosence
Treatment:
Frusemide (oedema)
ARB/ACE-I (reduce proteinuria by ↓ GFR)
SGLT2-I (reduce proteinuria by ↓ GFR)
Gout
(definiton + pathogenesis + diagnosis + treatment)
Accumulation of sodium-urae crystals within joints
Pathogenesis: Hyperuricaemia causing deposition of monosodium-urate crystals in the joints. Flare ups caused by immune response to urate crystals
Genes involved: SLC2A9 (for GLUT2 receptors), IL-37
Diagnosis:
Sudden onset of excruciating pain within the joint (often metatarsophalangeal)
Advanced gout: recurrent flare with persistent joint pain
Gold standard: presence of MSU crustals in synovial fluid taken from joint aspiration during flare
Serum urate >0.42mmol/L
Imaging via x-ray, ultrasound, CT shows urate crystals
Treatment:
Colchicine or NSAID’s (reduces inflammation)
Low dose allopurinol (lowers urate levels)
Ice (pain relief)
Lifestyle: limit alcohol, purines, sugar intake, weight loss in obese

Acromegaly
(definiton + signs + investigations + treatment)
Excess of GH, most often caused by secretory adenoma of somatotroph cells
Signs:
Prepuberty: extreme height (gigantism)
Postpuberty: growth of hands, feet, lower jaw (gaps between teeth), lips, nose
Cardiovascular disorders
Impaired glucose tolerance (diabetes)
Investigations:
High GH, high IGF-1, loss of diurnal GH pattern
Elevated glucose
Treatment:
Transphenoidal surgery and radiation (remove tumour)
Octreotide (somatostatin analogue)

Hyperprolactinemia
(defintion + signs + treatment)
Excess prolactin secretion, usually caused by prolactin secreting tumour, or drugs that reduce dopamine levels and transmission (e.g. antipsychotics)
Signs:
Women: cessation of periods, inappropriate lactation (galactorrhea)
Men: gynacomastia
Treatment:
In psychotic patients, alternative medications
Tumour: surgical removal
Hyperthyroidism (grave’s + toxic nodular disease + 1/2 hyperthyroidism)
(definiton + signs + treatment)
Grave’s disease: autoimmune condition causing anti-thyroid peroxidase Ab’s to stimulate TSH receptors
Toxic nodular disease: autonomous benign nodules which slowly increase thyroid production
Primary/ secondary hyperthyroidism: TSH or T4-producing adenoma
Signs:
Heat intolerance, weight loss, increased appetite, muscle weakness, diarrhoea, difficulty sleeping, anxiety
Grave’s: exopthalmos, goitre, High T3/T4, low TSH, diffuse uptake of radioactive iodine
Toxic nodular disease: nodular uptake of radioactive iodine
Treatment: carbimazole, surgical removal of thyroid gland, radioactive iodine, symptomatic relief (e.g. beta-blockers)
Cushing’s syndrome (cushing’s disease, ectopic tumour, adrenocrotical tumour)
Cushing’s disease: pituitary adenoma causing ACTH secretion
Ectopic tumour: ectopic tumour elsewhere in body secreting ACTH
Adrenocortical tumour: tumour in adrenal cortex secreting cortisol
Diagnosis:
Signs: central adiposity, moon face, oesteoporosis, poor wound healing and infections, stretch marks, low mood, hyperglycaemia, hypokalaemia, HTN
Cushing’s disease (pituitary adenoma): high cortisol, high ACTH, partial response to high dose DST, IPSS shows high ACTH
Ectopic tumour: high cortisol, high ACTH, no response to high dose DST
Adrenocortical tumour: high cortisol, low ACTH
Treatment:
Ketoconazole or metrapyrone
Withdraw glucocorticoid therapy if drug-induced
Addison’s disease (adrenal insufficiency)
(definition + diagnosis + treatment)
Autoimmune disease causing destruction of adrenal tissue
Diagnosis:
Signs: fatigue, aching, dizziness, weight loss, hypoglycaemia, hyperkalaemia, dark skin, dehydration, hypotension
Low cortisol, low aldosterone, high ACTH
Treatment: glucocorticoid replacement e.g. prednisone
Phaeochromocytoma
(definition + diagnosis + treatment)
Tumour of adrenal medulla causing hypersecretion of adrenaline and NA
Diagnosis:
Signs: episodic panic attacks, tachycardia, sweating, anxiety, HTN
High HMMA/ VMA (metabolites of catecholamines in urine)
Treatment:
Phenoxybenzamine (alpha adrenergic blocker)
Symptomatic relief: beta-blockers
Congenital adrenal hyperplasia
(definition + diagnosis + treatment)
Deficiency in 21-hydroxylase enzyme, prventing synthesis of hormones in the adrenal glands
Diagnosis:
Signs: polyuria, thirst, hypotension, stress, low BGC between meals, failure to thrive, precocious puberty
Low/ normal cortisol and aldosterone
High 17-OH-progesterone
Treatment:
Glucocorticoid replacement (cortisol): prednisone
Mineralocorticoid replacement (aldosterone): fludrocortisone
Acute lymphoblastic leukaemia
(definition + pathogenesis + diagnosis + treatment + prognosis)
Most common cancer in children, causing rapid proliferation of pre-B lymphoblasts in bone marrow
Pathogenesis: numerical or structural chromosomal changes causing bone marrow to be packed with rapidly dividing pre-B lymphoblasts which fail to mature
Diagnosis:
Anaemia, neutropenia, thrombocytopenia (pancytopenia)
Bone pain
Lymphadenopathy, splenomegaly, hepatomegaly
Blood film and biopsy: circulating lymphoblasts
Immunohistochemistry: TdT, CD10, CD19, CD20
Treatment: invasive chemotherapy followed by consolidation and maintenance
Prognosis: if hyperdiploidy (>50 chromosomes/ cell) - good prognosis
Follicular lymphoma
(defintion + pathogenesis + diagnosis + treatment + prognosis)
Low grade B-cell NHL causing B-cell lymphocytes to be arranged in follicular pattern in LN’s. Commonly affects >50yrs
Pathogenesis: translocation of BCL2 gene on chr 18 with IgH gene on ch 14, causing overexpression on BCL2 gene which inhibits apoptosis. This forms a clone of mature B cells which fail to die by apoptosis, resulting in geriatric overcrowding
Diagnosis:
Signs non-contiguous lymphadenopathy, fever, night sweats, weight loss
CD19 & CD20 positive immunohistochemistry
Treatment: Chemotherapy and/ or immunotherapy (e.g.rituximab)
Prognosis: not curable, survival 7-9 years

Hodgkin lymphoma
(definition + diagnosis + treatment + prognosis)
Neoplasms characterised by Reed-Steenberg cells
Diagnosis
High risk: young adults with EBV infection
Signs of contiguous lympadenopathy, weight loss, fever, night sweats
Blood film: Reed-steenberg cell surrounded by reactive cells
Treatment: systemic chemotherapy, sometimes with field radiotherapy
Prognosis: 5-year survival close to 100%

Hypercalcaemia (primary hyperparathyroidism, hypercalcaemia of malignancy, multiple myeloma, metabolic acidosis)
(definition + signs + treatment)
Primary hyperparathyroidism: parathyroid adenoma causing autonomous production of ACTH
Investigations: high Ca2+, low PO4, high PTH, high ALP
Hypercalcaemia of malignancy: tumour (e.g. SCC) secretes PTHrP
Investigations: high Ca2+ (high ALP, low PO4), low PTH,
Multiple myeloma: metastasis of bone cancer causing bone breakdown
Investigations: high Ca2+, high PO4, -ALP,
Metabolic acidosis: high H+ causes increase in ionised Ca2+
Investigations: high ionised Ca2+, -total Ca2+
Signs:
Fatigue
Weakness
Polyuria/ nocturia
Dehydration
Constipation
Nausea
Renal stones
Low mood
HTN
Bone disorders
CKD (from chronic high Ca2+)
Treatment:
Restore circulating volume
Parathyroidectomy (if hyper)
Bisphosphonates (_onate)
Calcitonin
Frusemide
Prednisone
Hypocalcaemia (vitamin D deficiency, hypoparathyroidism, metabolic alkalosis, renal failure, pseudohypoparathyroidism)
(definition + invesitgations + signs + treatment)
Vitamin D deficiency/ malabsorption: lack of vitamin D and thus calcitriol, prevent Ca2+ absorption from the gut
Investigations: Low Ca2+, low PO4, high PTH, high ALP
Hypoparathyroidism: lack of PTH (e.g. parathyroidiectomy)
Low Ca2+, low PTH
Metabolic alkalosis: low H+ which reduces ionised Ca2+ levels
Investigations: Low ionised Ca2+, normla total Ca2+,
Renal failure: inability to reabsorb Ca2+, and excrete PO4, creatine, urea
Investigations: low Ca2+, high PO4, high creatine and urea
Psuedohypoparathyroidism: end organ resistance to PTH
High PTH, low Ca2+, high phosphate, -ALP
Signs:
Pins and needles
Tetany/ convulsions
Numbness/ parasthesia
Stridor
Cataracts
Psychological disturbances
+ve Chvostek and Trousseau’s signs (face twitching upon tapping)
Treatment:
cholecalciferol, calcitriol
Thiazides
Chlamydia (definiton + complications + signs + diagnosis + treatment)
STI caused by chlamydia trachomatis
Complications (F): pelvic inflammatory disease causing infertility and ectopic pregnancy
Signs (mostly asymptomatic):
Painful ejaculation (M) and intercourse
Clear, mucoid penila/ vaginal discharge
Testicular swelling (F)
Bleeding between periods (M)
Diagnosis:
Nucleic acid amplification test (NAAT)
Culture of first pass urine samples or swabs: gram -ve, ovoid shape
Treatment:
Azithromycin 1g once OR
Doxycycline 100mg orally 2/ day for 7 days

Gonorrhea (definition + complications + signs + diagnosis + treatment)
STI caused by Neisseria gonorrhoeae
Complications (F): PID, infertility, neonatal infections
Signs:
Heavy yellow/white/ green purulent discharge
Burning sensation while urinating
Painful/ swollen testicles or vulva
Swollen glands/ burning in throat
Bleeding between periods or after intercourse
Conjuctivitis (neonates as well)
Diagnosis:
Microscopy and culture of swabs from pus secretions: intracellular gram-ve diplococci and oxidase +ve
Treatment: ceftriaxone 250mg and azithromycin 1g

Syphilis
(definiton + complications + symptoms + diagnosis + treatment)
STI caused by treponema pallidum
Complications:
Can progress to 2˚ syphilis causing condylomata lata (flat, wart-like lesions)
Late stage syphilis fatal if untreated
Symptoms:
Appear 2 weeks after infection
Chancre’s: small lesions on genitalia without inflammation
2˚ syphlis: disseminate to rest of the body 5-8 weeks after initial symptoms resolve
Late stage syphilis: insanity and death
Diagnosis:
Serology of blood sample using EIA, later confirmed by rapid plasma receptor antigens (RPR) or TPPA (T. pallidum plasma agglutination)
Swab of ulcer for T. pallidum (specialist only)
Treatment: benzathine penicilin (all stages)

Epilepsy + status epilepticus
(defintion + diagnosis + treatment)
Epilepsy = tendency to have convulsions/ transient abnormal events resulting from paroxysmal discharge of cerebral neurons
Diagnosis:
2 or more unprovoked seizures more than 24 hrs apart
Risk of another seizure after 1 unprovoked seizure the same as after 2 unprovoked seizure
In reflex epilepsy, at least 2 seizures in response to event (e.g. strobe lights)
Signs: focal or generalised involvement of the brain, impaired awareness and/ or motor involvement (depends on type of seizure)
Tonic clonic: generalised, impaired awareness with tense muscles and clonus
Absence seizures: focal with brief lack of response
EEG shows sudden sustained and rhythmic firing
Treatment:
Antiepileptic drugs (e.g. phenytoin, valproate, levetriacetam)
Vagal nerve stimulation (extreme cases)
Status epilepticus: medical emergency when seizure lasts >5 minutes or without rcovery period in between 2 seizures
Treatment: benzodiazepines, AED’s, intubation and ICU

Chronic kidney disease
(definition + causes + signs + treatment)
Any decrease in kidney function over a minimum of 3 months (typically eGFR <90ml/ min)
Causes:
HTN: sustained high intragllomerular P → thickening of renal a’s → ischaemic injury and sclerosis of glomeruli → decreased filtration
Diabetes: high BGC causing non-enzymatic glycation of BV's → hyaline arteriosclerosis of efferent arteriole → raised intraglomerular P → sclerosis of kidney → decreased filtration
CVD, smoking, age, obesity
Signs:
HIgh urea and creatinine
Hyperkalaemia (→ arrhythmia)
Hypocalcaemia (less conversion of vit D to calcitriol → PTH release → bone resoprtion of calcium → renal osteodystrophy)
HTN (decreased filtration → renin release → Na+ and water reasorption)
Anaemia (lack of EPO production)
Metabolic acidosis (lack of HCO3- production)
Treatment:
Treat underlying cause (e.g. ACE-I’s for HTN)
CVD risk management: b-blocker, SGLT2i, weight control, lipid lowering therapies
If oedema: frusemide
Dialysis or kidney transplant
EPO, calcitriol supplementation
Hypoglycaemia
(definiton + signs + treatment)
Glucose <4mmol/L (<3.1 in moderate, <2.2 in severe)
Signs:
Trembling
Intense hunger
Sweating
↑HR
Weakness
Confusion
Seizures/ coma
Treatment: medical emergency
Mild-moderate: oral glucose (15g candy or 200ml orange juice)
Severe: IM or SC glucagon
Type 1 diabetes mellitus (definition + signs + diagnosis + complications + management)
Autoimmune destruction of pancreatic beta cells, causing impaired insulin production
Signs
Polyuria
Excessive thirst (polydipsia)
Frequent urination
Severe: nail polish breath (keotacidosis)
Diagnosis: lab findings on 2 separate occasions, with appropraite signs and symptoms
Fasting BGC >7mmol/L, random BGC >11.1mmol/L
Glucose in urine
HbA1c >50mmol/L
Complications: muscle atrophy, ketoacidosis, diabetic retinopathy, diabetic neuropathy,
Management:
Insulin glargine + aspart: basal-bolus regimen (or insulin pump)
Glucose monitoring
Oral glucose available (in case of hypoglycaemia)
Type 2 diabetes mellitus
(definition + risk factors + complications + management)
impaired insulin secretion and insulin resistanc,e usually from result of prolonged elevated glucose
Risk factors
Adult onset
FH (polygenic disorder)
Obesity
Dyslipidaemia
HTN
Complications:
Cardiovascular disease (atherosclerosis causing ischaemia)
Diabetic retinopathy and neuropathy
Peripheal neruopathy causing infection and gangrene
Diabetic nephropathy
Cataracts
Management:
Dietary intervention and physical exercise
Metformin, empagliflozin, dulaglutide
Insulin if uncontrolled
Acute kidney injury (definition + causes + diagnosis + management)
Any abrupt decline in renal function within 48 hours, defined as
Increase in serum creatinine >27umol/L within 48 hrs or >50% over 7 days
Oliguria <0.5ml/ kg/ hour
Causes
Low perfusion (volume depletion, ventricular failure, vasodilation)
Inflammatory (e.g. GN)
Obstructive
Nephrotoxic
Diagnosis
↓ GFR
Oliguria
Metabolic acidosis with respriatory compensation
Hyperkalaemia → arrhythmia
Management
Correct underlying cause of AKI (e.g. N-saline if volume depletion)
Correct complications of AKI (e.g. NaHCO3 formetabolic acidosis)
AVOID giving ACE-I/ARB initially (will ↓GFR)
CVS + CKD protection - long-term
Herpex simplex encephalopathy
Complication of HSV infection causing encephalitis
Pathogenesis:
Viral transmission onto epithelial cells (mouth/ lips)
Retrograde transport via CN I or V
Remains latent in nucleus
Reactivation via anterograde transport
Transmission to temporal lobe causing inflammation
Diagnosis:
Signs: headache, fever, psychiatric symptoms, seizures, altering LoC
MRI shows inflammation of temporal lobe
CSF: DNA amplifcation of virus, moderate WBC and proteins
Complications: cerebral venous sinus thrombosis
Treatment: acyclovir